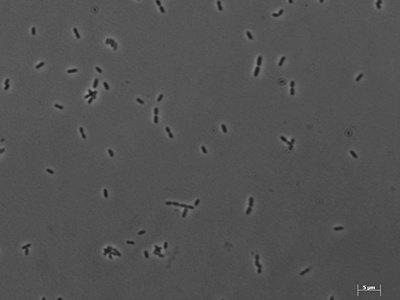
Methanobrevibacter

From boiling hydrothermal vents to salty lakes and the guts of animals, archaea occupy some of the planet’s most varied and surprising habitats. They’re often studied where conditions are extreme, but many species are common in soils, oceans, and host microbiomes too.
There are 20 Examples of Archaea, ranging from Archaeoglobus to Thermoplasma. The list is laid out so each entry shows Scientific name, Habitat, Metabolism to make comparisons quick and useful — you’ll find below.
Where are these archaea typically found and why does habitat matter?
Archaea are widespread: many are extremophiles in hot, acidic, or salty environments, while others live in soils, oceans, and animal digestive tracts. Habitat matters because it shapes metabolic strategies (e.g., sulfur reduction, methanogenesis) and tells you what ecological roles each organism plays.
How can I use the Scientific name, Habitat, Metabolism columns to compare species?
Use the Scientific name to identify taxonomy, Habitat to understand environmental preferences, and Metabolism to see how each species gets energy; together these columns let you quickly spot patterns like which groups produce methane or tolerate high temperatures.
Examples of Archaea
| Name | Scientific name | Habitat | Metabolism |
|---|---|---|---|
| Halobacterium | Halobacterium salinarum | Solar salterns, salt lakes | Halophile, aerobic heterotroph |
| Haloferax | Haloferax volcanii | Hypersaline lakes, salterns | Halophile, chemoorganotroph |
| Haloquadratum | Haloquadratum walsbyi | Hypersaline brines, salt pans | Extreme halophile, photoheterotroph |
| Halorubrum | Halorubrum lacusprofundi | Cold hypersaline lakes, Antarctic brines | Halophile, heterotroph |
| Methanobrevibacter | Methanobrevibacter smithii | Human gut, animal gut microbiomes | Methanogen, hydrogenotrophic |
| Methanosarcina | Methanosarcina mazei | Wetlands, sediments, anaerobic digesters | Methanogen, versatile methylotrophic/hydrogenotrophic |
| Methanopyrus | Methanopyrus kandleri | Hydrothermal vents, deep-sea vents | Hyperthermophilic methanogen |
| Methanocaldococcus | Methanocaldococcus jannaschii | Deep-sea hydrothermal vents | Hyperthermophilic methanogen |
| Methanococcus | Methanococcus maripaludis | Marine sediments, salt marshes | Hydrogenotrophic methanogen |
| Nitrosopumilus | Nitrosopumilus maritimus | Open ocean, marine water column | Ammonia-oxidizing chemolithoautotroph |
| Nitrososphaera | Nitrososphaera viennensis | Soil, terrestrial environments | Ammonia-oxidizing chemolithoautotroph |
| Sulfolobus | Sulfolobus solfataricus | Acidic hot springs, solfataras | Thermoacidophile, sulfur oxidizer |
| Pyrococcus | Pyrococcus furiosus | Deep-sea hydrothermal vents | Hyperthermophilic heterotroph |
| Pyrolobus | Pyrolobus fumarii | Deep-sea hydrothermal vents | Obligate hyperthermophile, chemolithoheterotroph |
| Thermococcus | Thermococcus kodakarensis | Deep-sea vents, hydrothermal habitats | Hyperthermophilic heterotroph |
| Archaeoglobus | Archaeoglobus fulgidus | Hydrothermal vents, oil reservoirs | Sulfate-reducing archaeon |
| Ferroglobus | Ferroglobus placidus | Hydrothermal vents, hot sediments | Iron-reducing chemolithotroph |
| Thermoplasma | Thermoplasma acidophilum | Acidic hot soils, solfataras | Acidophilic thermoheterotroph (no cell wall) |
| Nanoarchaeum | Nanoarchaeum equitans | Deep-sea vents, hydrothermal niches (symbiotic) | Obligate symbiont, dependent heterotroph |
| Ignicoccus | Ignicoccus hospitalis | Hydrothermal vents, sulfide-rich hot springs | Hyperthermophilic chemolithoautotroph |
Images and Descriptions

Halobacterium
A classic salt-loving archaeon found in saturated salt ponds and salted foods; it uses light-driven ion pumps and aerobic respiration to survive. Notable for colorful red blooms and robust salt-adapted proteins (NCBI Taxonomy).

Haloferax
A flexible model halophilic archaeon that grows in high-salt conditions and uses organic compounds for energy. It’s easy to culture and genetically tractable, making it a key organism for studying archaeal cell biology.

Haloquadratum
The distinctive square-shaped archaeon that dominates some salt ponds; it uses sunlight and organic molecules for energy. Notable for its flat, plate-like cells and high abundance in hypersaline ecosystems.

Halorubrum
A cold-adapted halophile found in Antarctic and other cold brines; it tolerates both high salt and low temperatures. Notable for proteins adapted to function in salty, cold environments.
Methanobrevibacter
A dominant archaeon in the human gut that consumes hydrogen and produces methane; influences gut fermentation and host physiology. Notable as a common human-associated methanogen linked to digestion.

Methanosarcina
A metabolically versatile methanogen able to use acetate, methyl compounds, and hydrogen. Often found in sediments and waste digesters; notable for large cell aggregates and adaptable metabolism.

Methanopyrus
An extreme hyperthermophilic archaeon that produces methane at very high temperatures near hydrothermal vents. Notable for growth near boiling temperatures and thermostable enzymes.

Methanocaldococcus
One of the first archaeal genomes sequenced; a heat-loving methanogen from vents. Notable for insights into early archaeal evolution and unique methane-producing pathways.

Methanococcus
A model methanogen used in laboratory studies; uses hydrogen and CO2 to make methane and is genetically manipulable. Notable for ecological role in marine and coastal methane cycling.

Nitrosopumilus
A widespread marine archaeon that oxidizes ammonia, contributing substantially to ocean nitrogen cycling and fixed-nitrogen budgets. Notable for high abundance and role in nitrification (GTDB, NCBI).

Nitrososphaera
A soil-dwelling ammonia-oxidizer that gains energy by oxidizing ammonia to nitrite; important in terrestrial nitrogen cycling. Notable as a cultivated representative of Thaumarchaeota.

Sulfolobus
An acid- and heat-loving archaeon from hot springs that oxidizes sulfur compounds. Notable for acid-stable enzymes, sulfur metabolism, and use as a model for archaeal genetics.

Pyrococcus
A rapidly growing hyperthermophile that thrives near vents using peptides and sugars; source of highly thermostable enzymes like DNA polymerases, useful in biotechnology.

Pyrolobus
Holds a record for growth at extremely high temperatures; it survives and grows at temperatures above 100°C near vents. Notable for extreme thermal tolerance and novel thermostable proteins.

Thermococcus
A model hyperthermophilic archaeon that metabolizes peptides and sugars; genetically tractable and used to study archaeal molecular biology and extreme enzyme functions.

Archaeoglobus
A sulfate-reducing archaeon that thrives in hot, anoxic environments and can oxidize hydrocarbons in subsurface habitats. Notable for linking archaeal metabolism to sulfur and carbon cycles.

Ferroglobus
An archaeon that couples oxidation of organic compounds or hydrogen to reduction of Fe(III), contributing to iron cycling in hot environments. Notable for metal-reducing metabolism among archaea.

Thermoplasma
A wall-less, acid- and heat-tolerant archaeon that lives in acidic hot environments; notable for lacking a cell wall and having unique membrane lipids.

Nanoarchaeum
A tiny archaeon that lives attached to another archaeon (Ignicoccus); it lacks many biosynthetic genes and depends on its host. Notable as one of the smallest known archaeal genomes.

Ignicoccus
A host archaeon for Nanoarchaeum and a high-temperature sulfur-metabolizing organism; notable for a unique outer membrane and symbiotic interactions with Nanoarchaeum.

